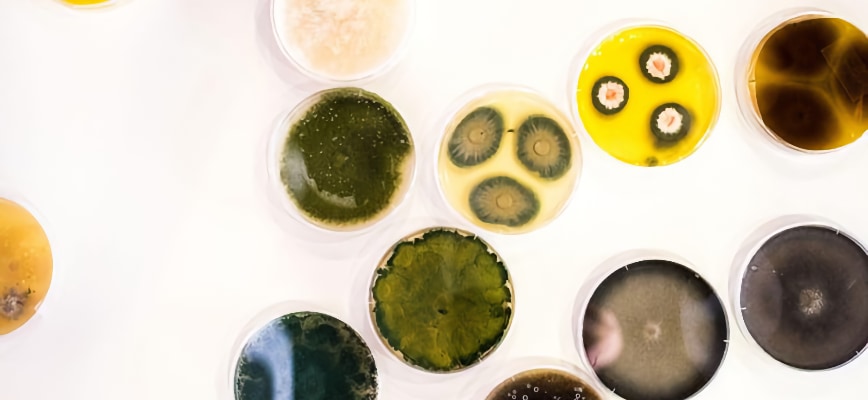
The Soil Microbes

Your Neighborhood Lawn Care Provider.

Dormant Grass, Active Soil: What's Still Happening Under Your Winter Lawn
- On December 15 2025
What's going on underneath the frozen soil? Most homeowners assume the entire system is "on pause" until spring. But here's the truth beneath the surface: Your lawn's still working diligently to rise strong and dense in the spring. Growth may have slowed, and the color may have dulled, but don't be fooled! Your lawn's microecosystem is working full-time to prepare for next year's growth.
It's Not Dead, It's Dormant!
We've heard “My grass died for the winter” and “Is it dead?” far too many times to count. We're here to put the story straight: In the winter, your lawn doesn't die- it's just dormant!Here's the difference: Dead grass won't come back and has no metabolic functions (it won't grow, won't uptake nutrients, and won't return in spring). Dormant Maryland grass is well and alive; it simply slowed down regular processes to survive the winter. You'll notice your grass goes into dormancy when it slows growth, appears brown, but stays firm in the soil when tugged.
Throughout the winter, dormant grass in Maryland still has plenty of chores to do before spring:
- Store nutrients and moisture for a spring green-up.
- Acclimate to the cold by storing sugars to protect its cellular structure.
- Protect against desiccation and snow mold.

The Science Behind Your Winter Lawn's Soil Activity
1. The Root System
You might not see them above the soil, but your grass roots are working harder than ever for your lawn! Your lawn's roots act as storage, keeping water and nutrients locked tight for the springtime.The roots store energy through carbohydrates, which are released in the spring for full, vibrant growth. Through photosynthesis, your lawn turns energy into sugar, and sugar into complex carbs like starch that can be stored for long periods of time.
They absorb any available water into their storage to ensure your lawn stays hydrated through a very dry winter. Harsh winds and plummeting temperatures leave lawns parched, but the roots step in to absorb any available water before the first freeze and any available liquid water when frost thaws.
2. The Soil Microbes
Your turfgrass isn't the only thing working its magic beneath the soil. Soil organisms are behind 90% of the services that healthy soil provides, so it's good to be mindful of their winter soil activity, too! Good bacteria and fungi might slow down a bit, but they're still decomposing organic material into usable nutrients for your lawn. All those lawn clippings, leaf litter, and weeds are broken down by bacteria and fungi. This breakdown releases vital nutrients (like nitrogen) back into the soil, slowly "pre-loading" the turf for spring consumption and lush green growth!

3. Winter Compaction
Over time, your soil will naturally compact with pressure, environmental changes, and more. Many factors in the wintertime can cause soil to compact, making it hard for grass roots to extend and thrive. Heavy foot traffic, children playing, or constant parking on a frozen, snow-covered lawn can cause severe compaction.Frost will freeze and thaw, seeping moisture into the soil. When the soil becomes moist, it will compact easier with pressure from feet, vehicles, pets, and more. As a general rule of thumb, try to avoid playtime or working in your yard over the winter months.

Smart Winter Lawn Care Science for Homeowners: Protecting the Chesapeake Bay at Every Step
During dormancy, cool-season grasses can't effectively use the nutrients in a fertilizer to grow and thrive. As a result, any fertilizer within these dates will likely run off into nearby bodies of water, like the Chesapeake Bay, instead of being absorbed.Maryland has a unique climate with certain winter conditions to consider as you tend to your lawn. The Chesapeake Bay is a very sensitive and valuable ecosystem that we should all work to protect. With this in mind, the Maryland Department of Agriculture has implemented fertilizer blackout dates from December 1 through March 1.
Winterizer's Influence on Spring Lawn Health
That special winterizer you applied before the first frost? It's not a gimmick- it's a way to feed your lawn and prepare it for launching off in the spring! If you didn't winterize your lawn this year, then it's time to prepare for next year. A year-round lawn care program can help you stay on top of your turfgrass's health for maximum growth and lush foliage.If you didn't apply a winterizer last year, now's the best time to level up your lawn care! Since the growing season has come to a pause, January is the best time to connect with a trusted lawn care company and discuss your service options. Winterizer is one solution to manage your lawn's spring health, but spring feedings and weed control are also essential aspects of a beautiful spring lawn.

Winter Preparation Now Pays Off Later
Want to master your winter lawn skills? Here are our best tips for Maryland homeowners looking to improve their seasonal care:
- Hydrate during warm days (avoid desiccation). Wake up to an unexpectedly warm winter day? Give your lawn a light watering! Winter is a critically dry time for grass, so top off its water reserves with a sprinkle (just don't go overboard, or else you can encourage mold growth).
- Feet off the lawn, please (prevent compaction). Give your lawn a little breathing room over the winter by avoiding any activities on your soil. This will keep your roots strong and your soil loose.
- Prepare for the first storm (clear debris). Pick up debris, put away lawn decorations, and winterize your sprinkler systems before the first snowfall. This will prevent your property from molding or cracking, and make springtime far easier for you!
- Avoid hazardous salt at all costs (protect against salt damage). Be mindful of getting rock salt too close to your lawn. While it's an effective driving safety measure, melted salt can severely disrupt your turfgrass's nutrient uptake capabilities.
